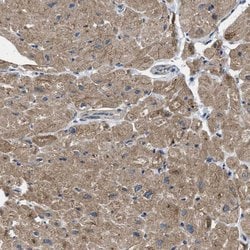
Invitrogen PDP1 Polyclonal Antibody 100 &mu;L; Unconjugated:Antibodies,

missing translation for 'onlineSavingsMsg'
Learn More
Learn More
Invitrogen™ PDP1 Polyclonal Antibody


Rabbit Polyclonal Antibody
Brand: Invitrogen™ PA554338
This item is not returnable.
View return policy
Description
Immunogen sequence: QDKFLVLATD GLWETMHRQD VVRIVGEYLT GMHHQQPIAV GGYKVTLGQM HGLLTERRTK MSSVFEDQNA ATHLIRHAVG NNEFGT Highest antigen sequence identity to the following orthologs: Mouse - 98%, Rat - 98%.
PDP1 is a Pyruvate dehydrogenase and helps catalyze phosphorylation of serine residues of E1 to inactivate the E1 component and inhibit the complex. Pyruvate dehydrogenase phosphatases catalyze the dephosphorylation and activation of the E1 component to reverse the effects of pyruvate dehydrogenase kinases. Pyruvate dehydrogenase phosphatase is a heterodimer consisting of catalytic and regulatory subunits.
Specifications
| PDP1 | |
| Polyclonal | |
| Unconjugated | |
| PDP1 | |
| [Pyruvate dehydrogenase [acetyl-transferring]]-phosphatase 1, mitochondrial; FLJ32517; FLJ56179; Gm1024; MGC119646; PDH; PDP; PDP 1; PDP1; PDPC; PDPC 1; PPM2A; Ppm2c; Protein phosphatase 2C; protein phosphatase 2C, magnesium dependent, catalytic subunit; protein phosphatase 2C, magnesium-dependent, catalytic subunit; protein phosphatase, Mg2+/Mn2+ dependent 2A; pyruvate dehydrogenase; pyruvate dehydrogenase (Lipoamide) phosphatase-phosphatase; pyruvate dehydrogenase phosphatase catalytic subunit 1; pyruvate dehydrogenase phosphatase isoenzyme 1; pyruvate dehydrogenase phosphatase isoenzyme 2; pyruvate dehydrogenase phosphatase, catalytic subunit 1; pyruvate dehyrogenase phosphatase catalytic subunit 1 | |
| Rabbit | |
| Antigen affinity chromatography | |
| RUO | |
| 54704 | |
| Store at 4°C short term. For long term storage, store at -20°C, avoiding freeze/thaw cycles. | |
| Liquid |
| Immunohistochemistry (Paraffin), Western Blot, Immunocytochemistry | |
| 0.1 mg/mL | |
| PBS with 40% glycerol and 0.02% sodium azide; pH 7.2 | |
| Q9P0J1 | |
| PDP1 | |
| Recombinant protein corresponding to Human PDP1. Recombinant protein control fragment (Product #RP-91575). | |
| 100 μL | |
| Primary | |
| Human | |
| Antibody | |
| IgG |
Product Content Correction
Your input is important to us. Please complete this form to provide feedback related to the content on this product.
Product Title
Spot an opportunity for improvement?Share a Content Correction